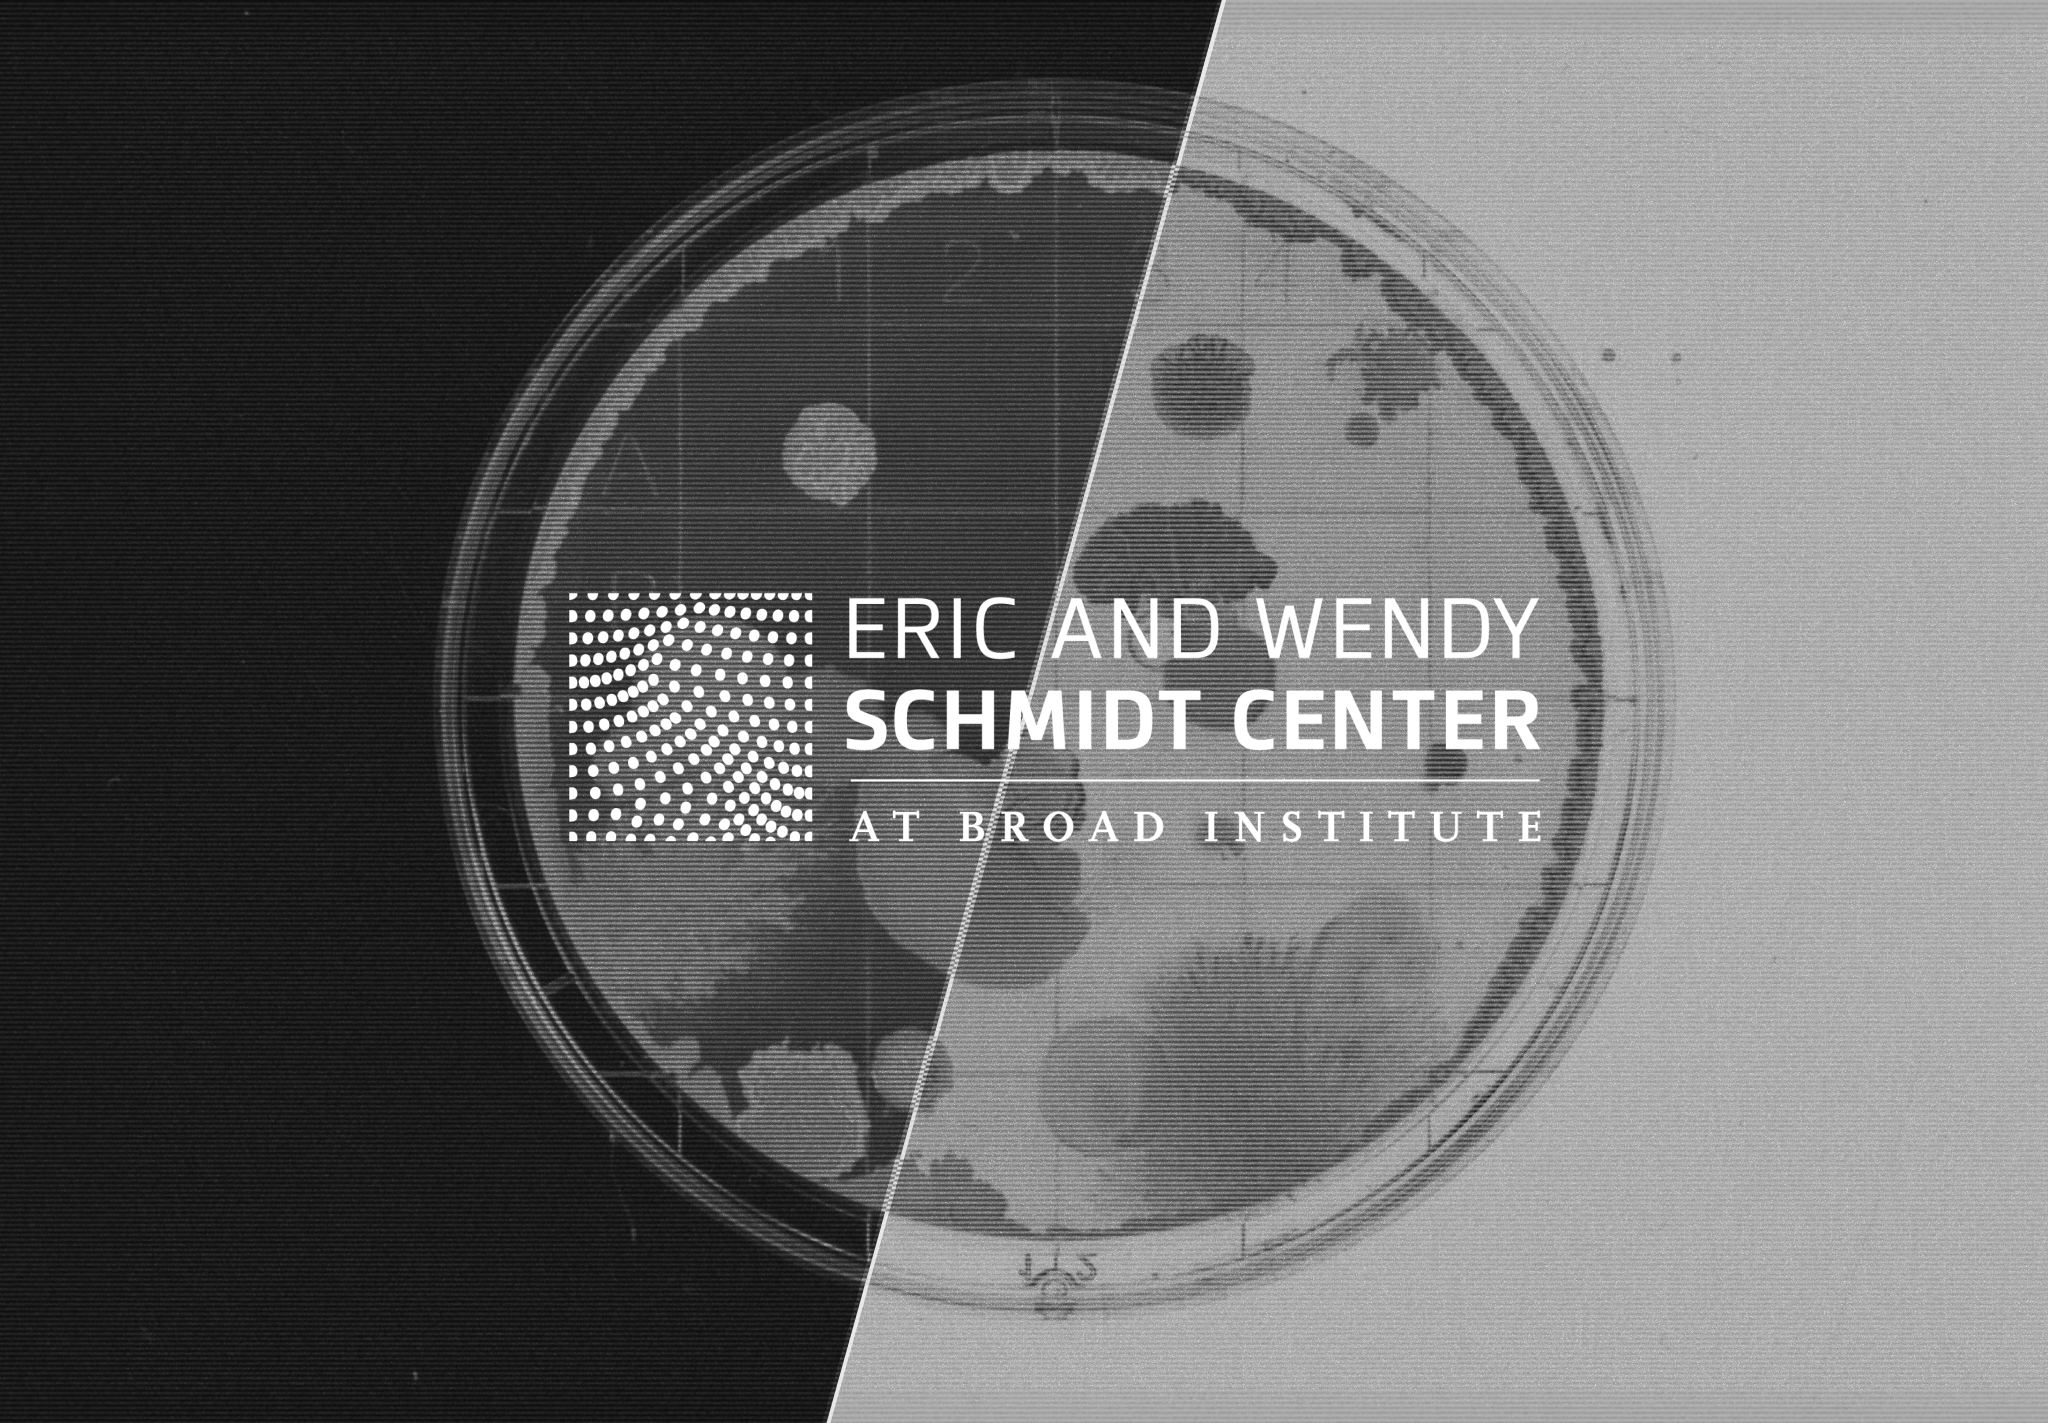

Proof in action
Explore our case studies and see how our innovative technology is driving success and empowering creators in the real world
Real-Time FX Pricing
Win more client flow with tighter, faster pricing. Reduce slippage and optimize inventory holding times in volatile markets.
- <60μs Latency: Ultra-low latency pricing to prevent stale quotes and slippage.
- Tighten Spreads: Adapts to volatility instantly, allowing you to win more client flow.
- Inventory Management: sharper predictive signals reduce toxic inventory hold times.

Computer Vision in Healthcare
How the Broad Institute engaged 1,000 researchers to build models that infer expensive molecular data from cheap tissue images, advancing the early diagnosis of colorectal cancer.
- Accuracy of our customer benchmark x2
- Gene Panel experiments based on the community models
- Hopefully leading to improved diagnosis, prognosis, and treatment of cancer
Market Regime Detection
How ADIA Lab partnered with Crunch to crowdsource novel algorithms that detect "Structural Breaks"—invisible changes in market rules—achieving double-digit accuracy improvements.
- Regime Detection: Identifying invisible "Change Points" before P&L impact.
- Adaptive AI: Models that "unlearn" irrelevant history to adapt instantly.
- Double-Digit Gains: Outperforming standard baselines by double-digit percentages.

Causal AI in Finance
How ADIA Lab partnered with Crunch to advance the field of Causal AI, identifying robust drivers in high-dimensional data that standard machine learning misses.
- Built the world’s best Causal Discovery Algorithm to date
- Collaborated with 2021 Economics Nobel Laureate
- Outperformed by 17% ADIA’s internal team

